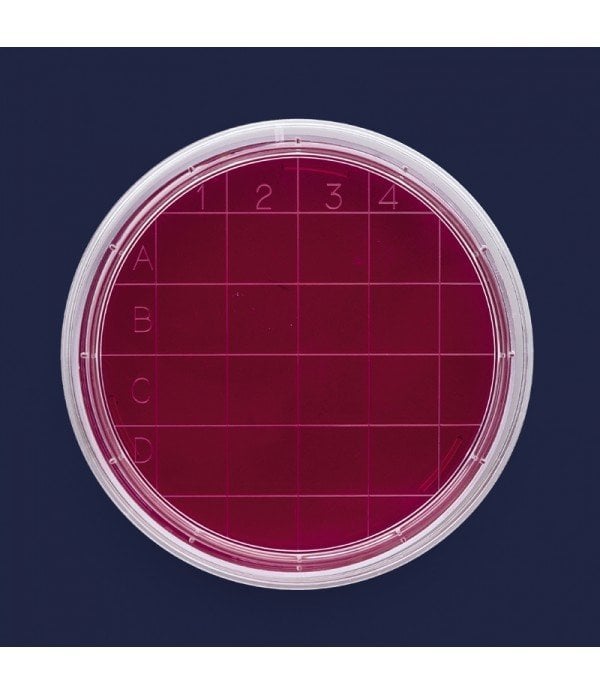

ISOLAB 081.04.160 petri kutusu rodak - 60 mm - gamma steril
99,46 EUR + KDV
6.387,70 TL
ISOLAB 081.04.160 petri kutusu rodak - 60 mm - gamma steril
PETRI KUTUSU - “rodak”
●Deri, çalışma tezgahları, ve diğer tüm yüzeylerdeki bakteriyolojik kontaminasyon testlerinde kullanılmak üzere son derece şeffaf polistirenden üretilirler. Aynı zamanda koloni sayımıda yapılabilir.
●İnsan eli değmeden tam otomatik makinalar ile üretilirler.
●İdeal gövde formları otomatik dolum makinaları ile tam uyumlu çalışmayı garanti eder.
●Kutu tabanında yer alan kabartma sayım indeksi kontamine partiküllerin cm2 alanda sayılmalarına olanak sağlar.
●Aseptik petri kutuları bakterilerden arındırılmış 10.000 sınıfı steril alanlarda yüksek sterilite kontrolü altında üretilirler.
●Steril petri kutuları bakterilerden arındırılmış 10.000 sınıfı steril alanlarda üretildikten sonra gama ışınları ile yeniden steril edilirler.
●Steril petri kutuları “DNase, RNase, pirojen” içermediklerini belgeleyen test sertifikası ile teslim edilirler.
Çap x Yükseklik : 66 x 15 mm
* 1 paket fiyatıdır. Pakette 500 adet vardır.

PETRI KUTUSU - “rodak”
●Deri, çalışma tezgahları, ve diğer tüm yüzeylerdeki bakteriyolojik kontaminasyon testlerinde kullanılmak üzere son derece şeffaf polistirenden üretilirler. Aynı zamanda koloni sayımıda yapılabilir.
●İnsan eli değmeden tam otomatik makinalar ile üretilirler.
●İdeal gövde formları otomatik dolum makinaları ile tam uyumlu çalışmayı garanti eder.
●Kutu tabanında yer alan kabartma sayım indeksi kontamine partiküllerin cm2 alanda sayılmalarına olanak sağlar.
●Aseptik petri kutuları bakterilerden arındırılmış 10.000 sınıfı steril alanlarda yüksek sterilite kontrolü altında üretilirler.
●Steril petri kutuları bakterilerden arındırılmış 10.000 sınıfı steril alanlarda üretildikten sonra gama ışınları ile yeniden steril edilirler.
●Steril petri kutuları “DNase, RNase, pirojen” içermediklerini belgeleyen test sertifikası ile teslim edilirler.
Çap x Yükseklik : 66 x 15 mm
* 1 paket fiyatıdır. Pakette 500 adet vardır.

Bu ürüne ilk yorumu siz yapın!